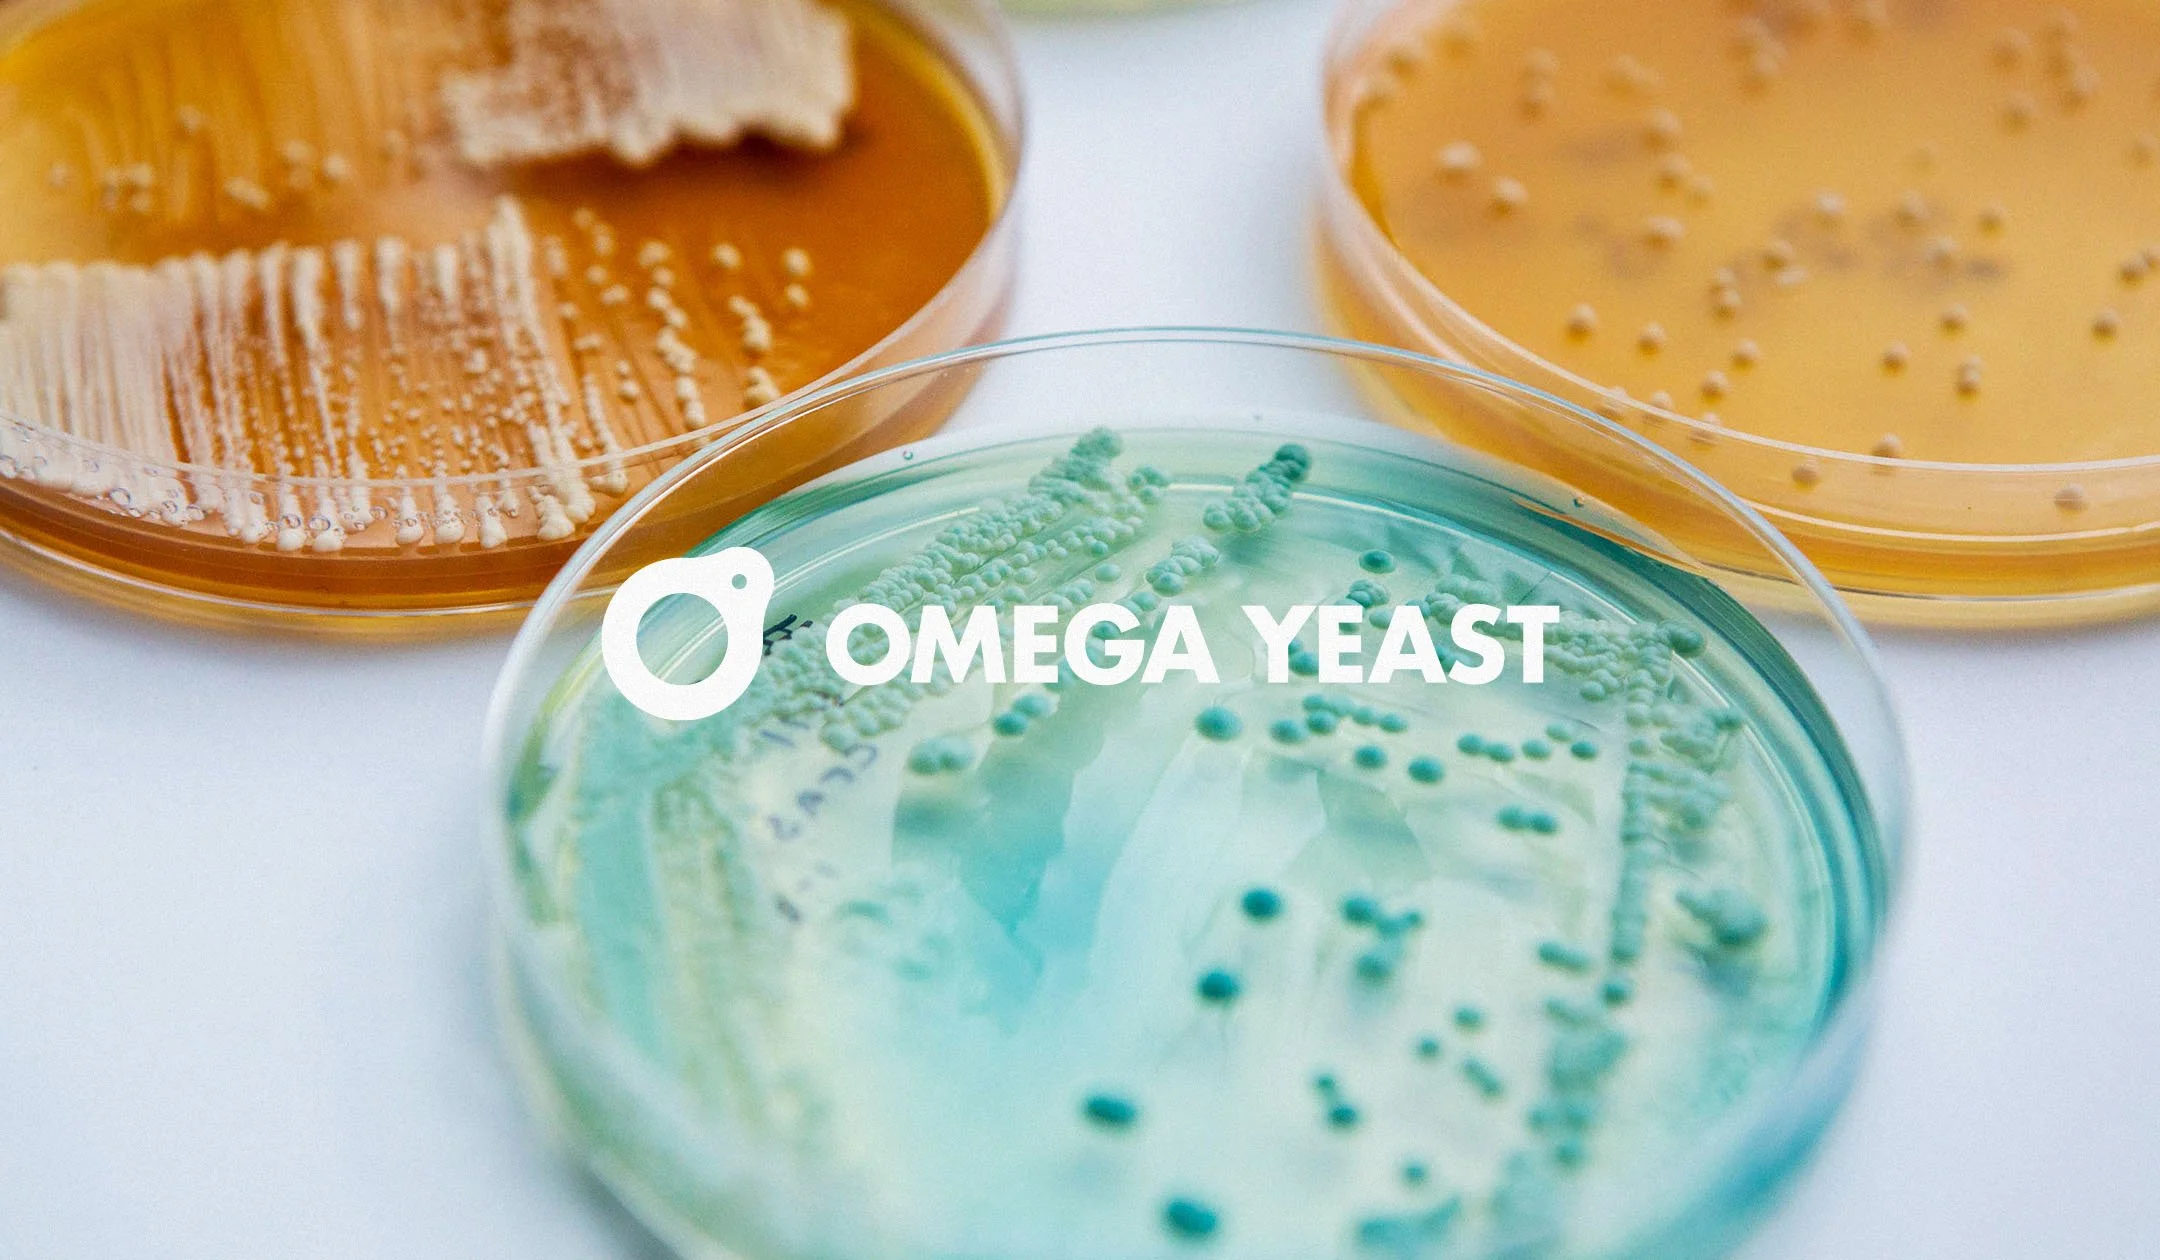

Omega Yeast Labs
Info
Based in Chicago and St. Louis, Omega Yeast produces more than 75 liquid yeast strains for both probrewers and homebrewers alike. They’ve built a name for themselves by delivering fresh, reliable yeast, along with unique strains you won’t find anywhere else. Building off a strong visual foundation, Omega trusted us to help grow and evolve the brand over the last few years, ultimately supporting their successful acquisition by an international company.
CREDITS
Dexter Stevens
Designer
Kyle Eertmoed
Director of Brand Design
Kim Knoll
Designer
Brett Burwell
Web Developer